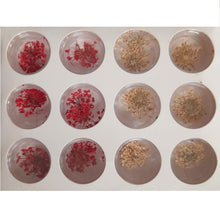
Load image into Gallery viewer, Nail Art - Dried Flowers

UK Standard Deliveries [1 - 5 working days]
Free delivery when you spend £90 or over, £5.99 for orders under £90.
Orders placed before 2pm Monday - Friday (UK Time), except public holidays and weekends, are dispatched the same day. Subject to your payment being processed and stock availability.
Orders placed after 3pm during the weekdays or at weekends will be processed the next following working day. Please note - Friday late orders will not be processed until Monday.
All orders usually delivered within 5 working days, Monday to Friday, 8am - 5pm. Some couriers may deliver slightly earlier or later.
Couriers we use for standard deliveries include Royal Mail, APC Overnight, DHL or DPD.
Upon dispatch, we will notify you via email that the order has been dispatched and also provide a tracking number so that you can track your parcel(s).
In addition, the courier service may contact you via email and/or text message with further delivery instructions and the time window for delivery. This will largely depend on their own delivery service policy.
Upon the driver’s arrival, they may require a signature from the recipient aswell as take a picture of the item at your door as proof of delivery.
Should you not be available at the time of delivery then re-delivery is automatically scheduled next working day. After several of missed attempts then your order may get returned back to us for further instructions. Please get in contact with us immediately to avoid further delays.
We have a 14-day return policy, which means you have 14 days after receiving your item to request a return.
To be eligible for a return, your item must be in the same condition that you received it, unworn or unused, with tags, and in its original packaging. You’ll also need the receipt or proof of purchase.
You can always contact us for any return questions at sales@asianailsupply.co.uk.
Damages and issues
Please inspect your order upon reception and contact us immediately if the item is defective, damaged or if you receive the wrong item, so that we can evaluate the issue and make it right.
Exceptions / non-returnable items
Certain types of items cannot be returned, such as custom products (i.e, personalized items like flatten brushes) and personal care goods (such as Nail polishes, Gel polishes and Liquid chemicals) due to hygiene reasons. Please get in touch if you have questions or concerns about your specific item.
Unfortunately, we cannot accept returns on sale items or gift cards.
Exchanges
The fastest way to ensure you get what you want is to return the item you have, and once the return is accepted, we will give you instructions on how the exchange will take place.
Refunds
We will notify you once we’ve received and inspected your return, and let you know if the refund was approved or not. If approved, you’ll be automatically refunded on your original payment method. Please remember it can take some time for your bank or credit card company to process and post the refund too.
Stock error
We may every effort to ensure the information of stock availability is accurate but there may be occasions, whereby the product item may display in-stock online but the physical stock may have ran out or is no longer available. However, if this occurs then we will automatically refund the item in question and on your fulfillment confirmation will display accordingly.